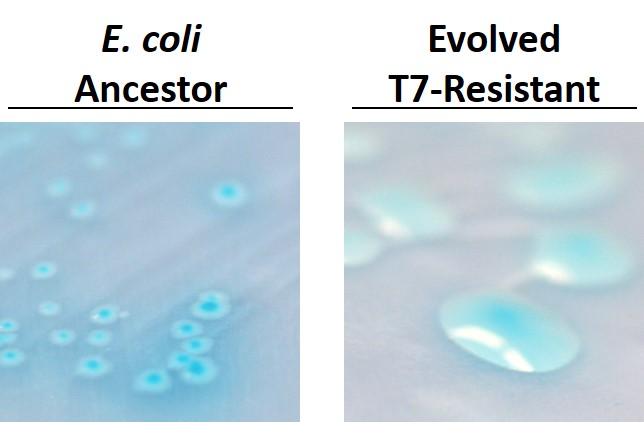

Bacteriophage: Serving up bacterial buffets
Published in Microbiology

By Lisa Fazzino
Bacteriophage, or viruses that infect bacteria, are everywhere! They are thought to kill 10-25% of the bacteria in Earth’s oceans every day1, meaning these viruses can significantly affect bacterial communities. Bacteriophage (phage) typically have a narrow host range; however in addition to directly killing cells, previous work has shown that phage can indirectly impact the abundance of nonhosts by altering the strength of competition between bacteria.2-4 I study how phage affect cooperative cross-feeding systems in which metabolites are exchanged between species. Our lab has developed a model cross-feeding co-culture of Escherichia coli and Salmonella enterica.5 These two bacterial strains form an obligate mutualism in which acetate and methionine are exchanged. We found that phage infection can impact the nonhost partner in diverse and under-appreciated ways. In some cases, the nonhost is prevented from growing until phage resistance evolves in the host. In other instances, the nonhost reaches higher final yields when its partner is decimated by phage infection, meaning phage infection breaks the cross-feeding dependency.

Mathematical modeling and previous work from our lab led us to predict that phage attack of either member of our cross-feeding coculture would slow community growth, but have little effect on final yields.6 Bench experiments showed that both E. coli-specific T7 phage and S. enterica-specific P22vir phage did indeed slow community growth, but there were some unexpected impacts on final yields. When E. coli was infected with T7, S. enterica reached HIGHER yields than in co-cultures without phage. The mathematical model completely missed the surprising benefit to S. enterica during T7 phage infection.

We used a combination of experiments and mathematical modeling to figure out two reasons why S. enterica benefited from phage infection when it should have suffered with its cross-feeding partner E. coli. First, the S. enterica consumed the cellular debris released by phage by lysed E. coli. We showed that dead E. coli were readily consumed by S. enterica, but dead S. enterica were hardly used by E. coli. Basically, S. enterica is happy to go to an E. coli carbon buffet, but E. coli is a picky eater - because it requires methionine from S. enterica, not carbon.
Second, PARTIAL phage resistance increased the benefit to S. enterica. E. coli isolates from the end of our T7 experiments were all mucoid! Mucoidy is extra exopolysaccharide that acts as a goopy physical barrier limiting phage infection. Mucoid E. coli were able to grow in the presence of phage, but the phage were still able to infect at some rate. Our models showed that partial resistance led to continual release of cellular debris over the course of growth, in contrast to the small burst of cellular debris released from sensitive cells right after phage addition. To continue the metaphor, partial resistance allowed the carbon buffet to be continually restocked by phage.
It was surprising to find that phage could either constrain OR enhance growth of a cross-feeding partner. We are excited about the new questions this work has raised. Do these ecological dynamics continue through evolutionary time? Would multiple phage strains better prevent community-level bacterial growth? Overall, considering how the ecology and metabolism of phage hosts change consequences of infection could reveal new ways that phage control bacterial communities - including bacterial communities important to human health or food production.
For full paper see: Fazzino et al ISME J (2019) Oct 2
References:
(1) Suttle. Nat Rev Microbiol. (2007) 5, 801–437
(2) Harcombe & Bull. AEM (2005) 7:9, 5254-5259
(3) Brookhurst et. al. BMC Ecology (2006) 6:19
(4) Yu et. al. Environmental Science & Technology (2017) 51, 5270−5278
(5) Harcombe. Evolution (2010) 64-7, 2166–2172
(6) Adamowicz et al. The ISME J (2018) 12:11, 2723-2735
Please sign in or register for FREE
If you are a registered user on Research Communities by Springer Nature, please sign in